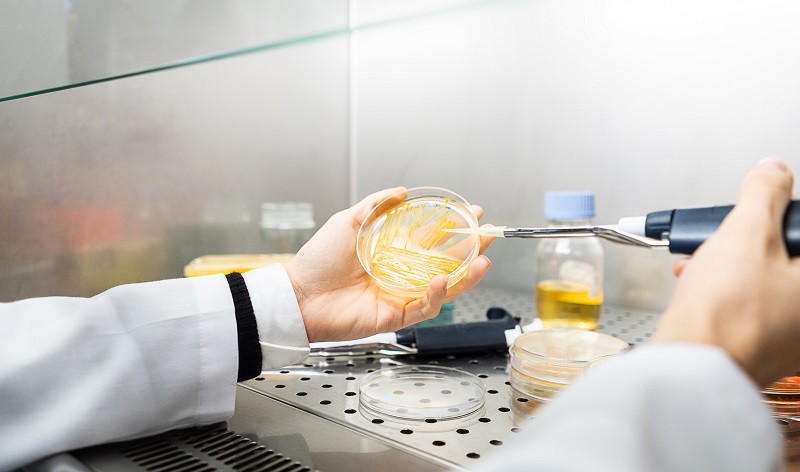
Laboratorio microval

Micro-Val. I batteri mangia-plastica per riciclare i rifiuti organici

Photo by Ishan @seefromthesky on Unsplas
Liberare i rifiuti organici dai residui di plastica a base di polietilene grazie ai batteri in grado di “digerirla”.
È l’obiettivo di Micro-Val (MICROrganismi per la VALorizzazione di rifiuti della plastica), il progetto ideato da un team tutto al femminile dell’Università di Milano-Bicocca, guidato da Jessica Zampolli, assegnista di ricerca presso il laboratorio di Microbiologia diretto dalla professoressa Patrizia Di Gennaro del Dipartimento di Biotecnologie e Bioscienze.
Si tratta del quarto progetto lanciato quest'anno da Biunicrowd, il programma di finanza alternativa dell’Ateneo, promosso per consentire a studenti, ex studenti, docenti, ricercatori e dipendenti di realizzare progetti innovativi e idee imprenditoriali attraverso campagne di raccolta fondi su Produzioni dal Basso, prima piattaforma di crowdfunding e social innovation.

Il team del progetto
L’obiettivo economico di Micro-Val è di 9500 euro, risorse che serviranno per la messa a punto del primo trattamento italiano di trasformazione e degradazione microbiologica della plastica a base di polietilene applicabile negli impianti di gestione dei rifiuti.
Il 65% dei composti plastici prodotti globalmente è rappresentato dalle plastiche a base di polietilene, sia per le ottime caratteristiche chimico-fisiche e meccaniche, sia per i bassi costi di produzione del materiale.
Purtroppo, questi materiali plastici contaminano anche i rifiuti organici, nella fase della loro raccolta differenziata. Spesso, infatti, per errore i materiali non biodegradabili si ritrovano nei rifiuti dell'umido perché non vengono correttamente differenziati all’origine.
«Una soluzione per la riduzione di queste plastiche che contaminano i rifiuti organici urbani – spiega Jessica Zampolli - è la rottura e la trasformazione delle catene del polimero. Questo processo può avvenire grazie all'utilizzo di microrganismi in grado di biotrasformare e biodegradare, almeno parzialmente, il polietilene».
Micro-Val si articolerà in due fasi.
Le prove in laboratorio serviranno a studiare le proprietà dei batteri mangia-plastica e a valutarne la loro efficacia per liberare la frazione organica dei rifiuti solidi urbani (FORSU) dalla componente di rifiuto indesiderato, costituita per lo più da polietilene (circa 5 per cento). Nella seconda fase, il team di ricerca verificherà la possibilità di applicare il trattamento biologico per uno scale-up in un impianto in collaborazione con un'azienda leader nel settore del recupero e il riciclo di rifiuti.
Il progetto prevede anche lo sviluppo di un’applicazione per smartphone che fornirà consigli all'utente nello svolgimento della raccolta differenziata, permettendo a ogni cittadino di contribuire all'ambizioso obiettivo del team di ricerca.
Micro-Val ha ottenuto il sostegno di Corepla, il Consorzio nazionale per la raccolta, il riciclo e il recupero degli imballaggi in plastica. Se la campagna raggiungerà almeno la metà dell'obiettivo fissato, scatterà il cofinanziamento da parte del Consorzio.
«La partnership con l'Università Bicocca per il progetto #BiUniCrowd conferma l'impegno di Corepla a supportare attività di open innovation e sostenere e condividere nuove idee e tecnologie – afferma Antonio Protopapa, direttore ricerca e sviluppo di Corepla – anche al di fuori dell'ambito consortile. Il tema dell'innovazione nel suo complesso è per il Consorzio un nodo centrale e particolarmente sfidante e la sinergia con il mondo accademico rappresenta il terreno ideale per la crescita della sostenibilità ambientale come valore condiviso. Oggi più che mai è necessario puntare sui giovani, che saranno i cittadini del domani, e che sono portatori di cambiamenti positivi e promotori di azioni che possono rendere concreto il concetto di economia circolare».
Per maggiori informazioni e sostenere “Micro-Val”:
Resta connesso con l'innovazione sociale
Se questo contenuto ti è stato utile, iscriviti alla nostra newsletter settimanale: ogni lunedì, bandi, opportunità e progetti direttamente nella tua casella.
📧 Iscriviti alla newsletter
💼 Seguici su LinkedIn e Facebook
📱 Unisciti al canale Telegram
Tutti i contenuti di Innovazione Sociale sono accessibili gratuitamente. Chi collabora con noi sostiene un modello che dedica spazio a nuove realtà, mantiene rubriche come Bandi e finanziamenti e IMPATTI libere per tutti, e garantisce accesso universale all'informazione di qualità.
Dicono di noi...
Ultimi Articoli
- Tuturano diventa hub di rigenerazione territoriale con XYZ – Viaggio intorno al sole 19 Febbraio 2026
- Progettare luoghi, costruire comunità: città e territorio nella transizione sostenibile 18 Febbraio 2026
- Competitivi perché sostenibili. La geografia dell’eco-innovazione e dei brevetti green in Italia 17 Febbraio 2026
- I giovani nel cuore del policy-making con la Città metropolitana di Milano 17 Febbraio 2026
- Premio giornalistico Riccardo Bonacina: nuove voci per la narrazione sociale 16 Febbraio 2026